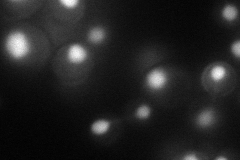
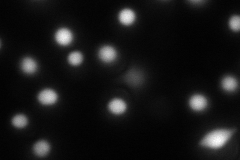
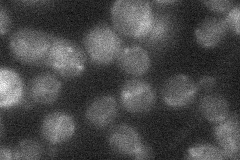

View description
Class II abasic (AP) endonuclease involved in repair of DNA damage; homolog of human HAP1 and E. coli exoIII
Localization:
Intensity:
Fold change:
Significance:
-
C’ GFP library in SD

below threshold16.7 -
N' NOP1pr-GFP in SD
nucleus70.8514 -
N' TEF2pr-mCherry in SD
nucleus73.41 -
N' NATIVEpr-GFP in SD
mitochondria20.2983 -
N' TEF2pr-VC and Cyto-VN in SD

nucleus31.2841 -
C’ GFP library in SD+DTT

cytosol18.041.08No -
C’ GFP library in SD+H2O2

cytosol15.030.89No -
C’ GFP library in Starvation Media

cytosol12.950.77No -
C’ GFP library on the background of Pup2-DaMP

below threshold -
C’ GFP library on the background of CCT mutant

below threshold19.48091.1659No
